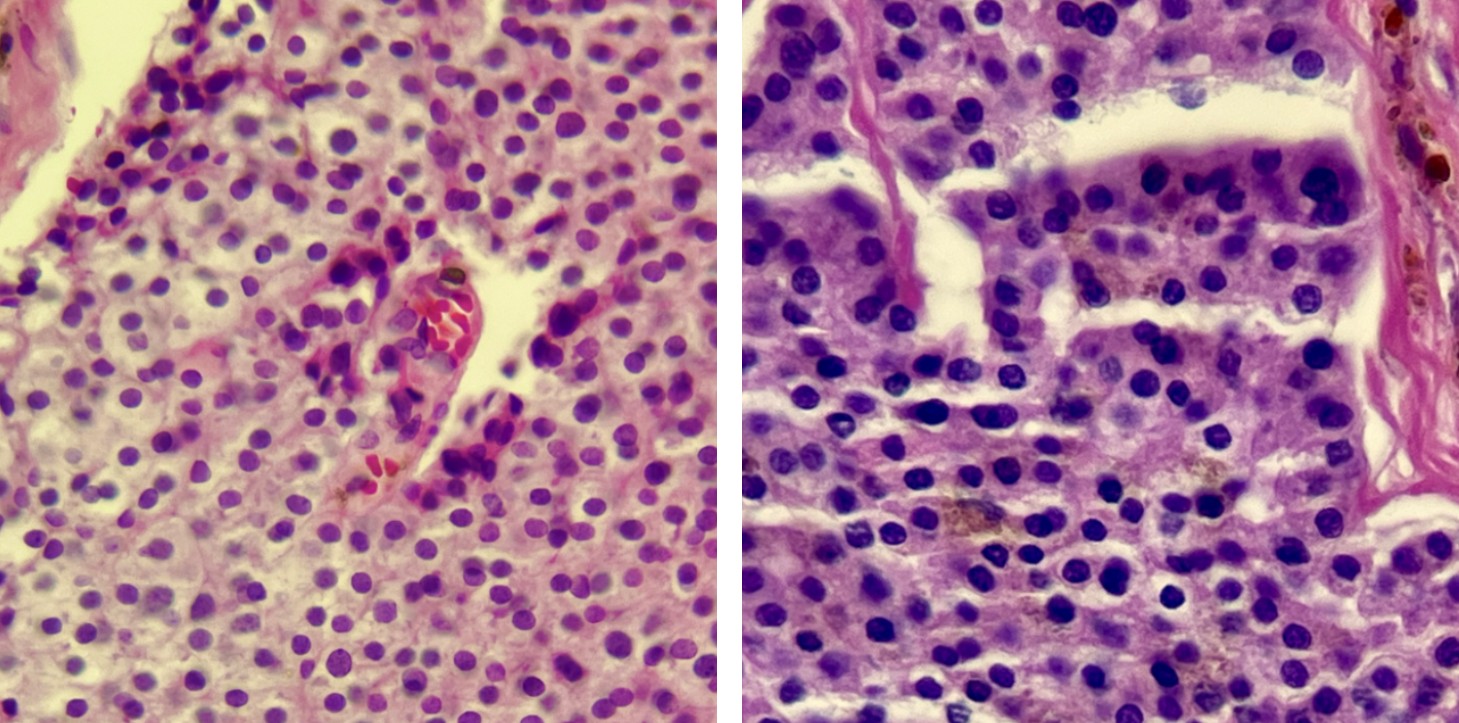

Mujer de 47 años.
Inició su padecimiento actual hace cuatro meses con aumento de volumen en glándula tiroidea, indolora, sin afección a la deglución o fonación.
Estudios de laboratorio sin datos fuera de parámetros.
Se realizó ultrasonido con toma de biopsia por aspiración con aguja fina.
Se encontró nódulo intratiroideo de 4 cm de diámetro, TIRADS 3.

1.- ¿Cuál es el diagnóstico más probable?
a) Tumor trabecular hialinizante.
b) Carcinoma medular de tiroides.
c) Paraganglioma.
d) Adenoma paratiroideo intratiroideo.
2.- ¿Qué panel de inmunohistoquímica sugeriría para confirmar su diagnóstico?
a) Cromogranina, PS100, TTF1, Calcitonina, GATA3.
b) Sinaptofisina, CK20, CK7, TTF1, Calcitonina.
c) TTF1, tiroglobulina, PAX8, INSM1, CDX2.
d) CD56, TTF1, PAX5, Napsin A, SOX10.
3.- ¿Cuál es el rango reportado de sensibilidad de la biopsia por aguja fina de lesiones tiroideas?
a) 15 – 65 %
b) 65 – 99 %
c) 95 – 100 %
d) 50 – 60 %